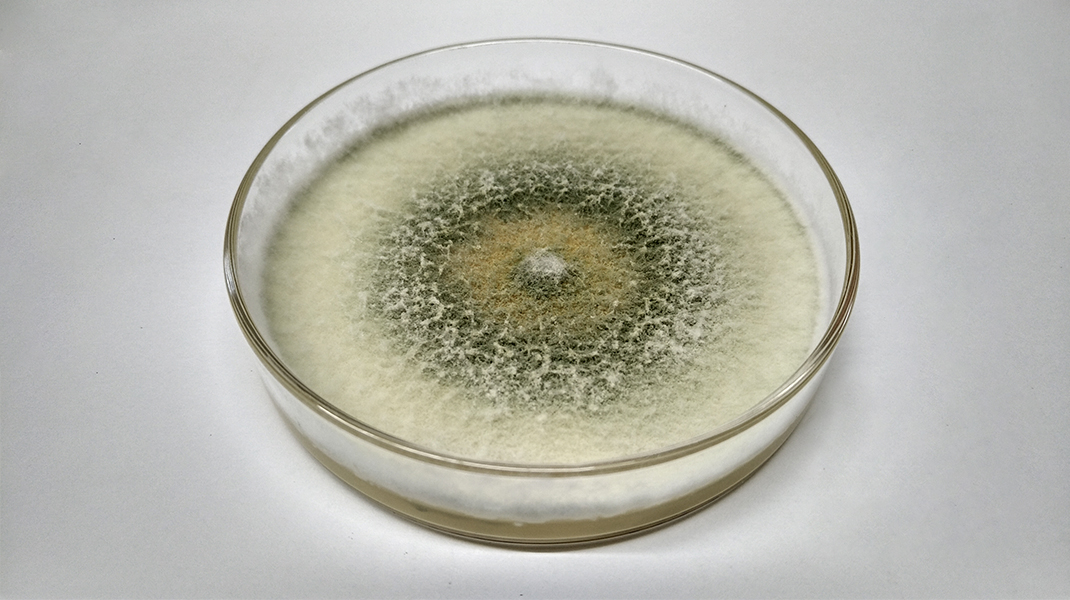
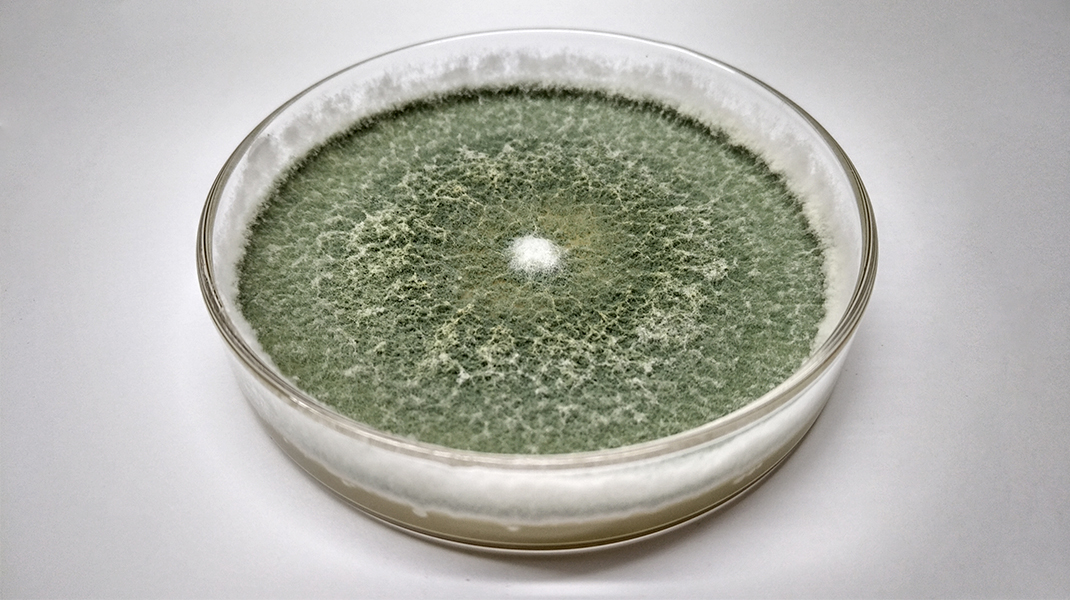
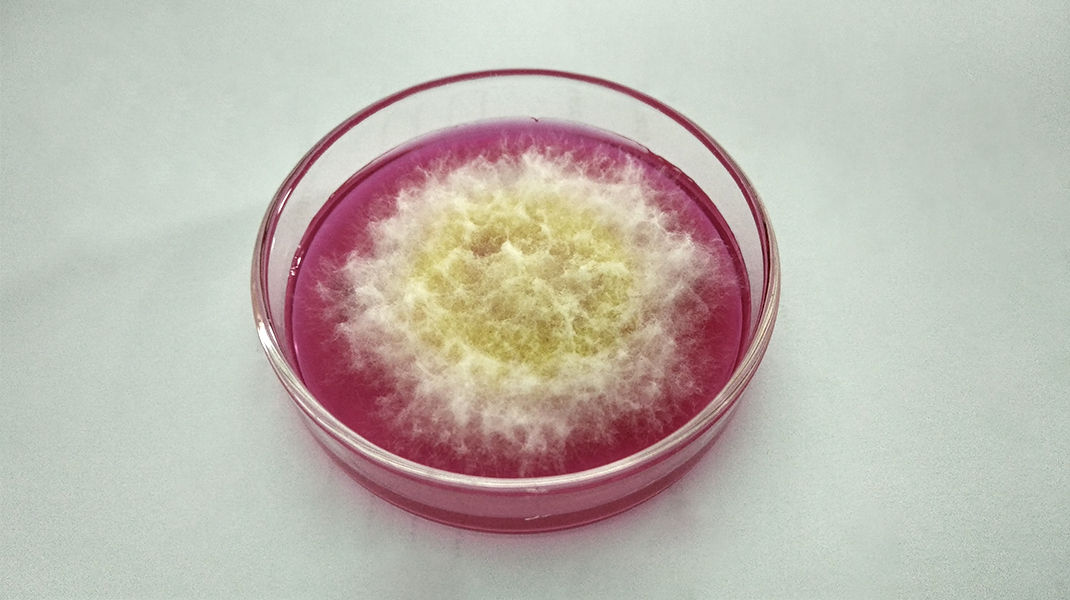
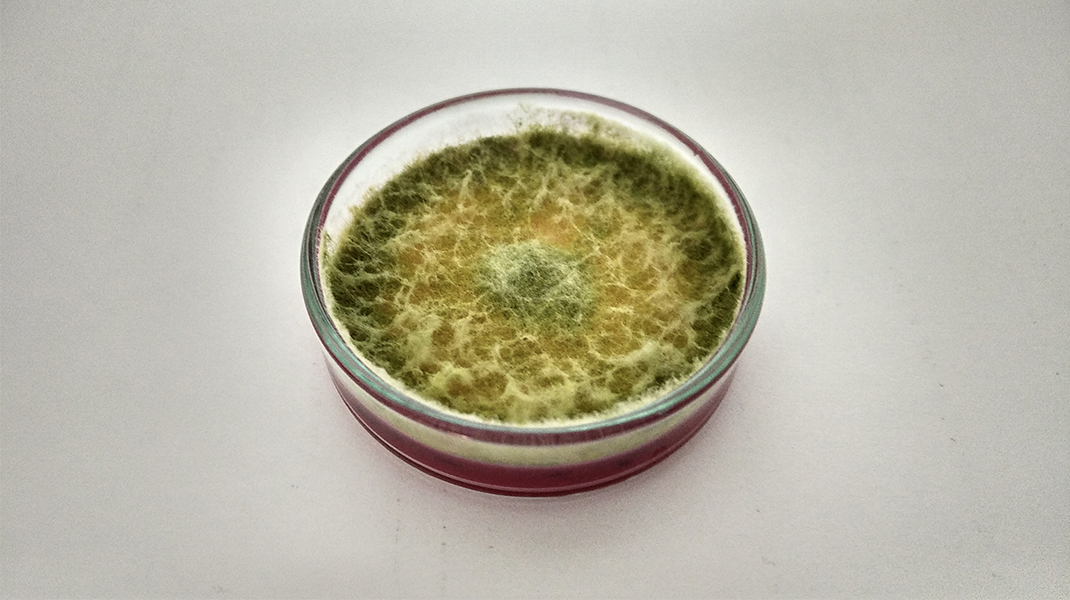

Las características macroscópicas de Trichoderma (aspecto y forma de la colonia, color del micelio, producción de pigmentos y/o exudados, entre otras) no son suficientes para lograr una buena identificación.
Es necesario hacer observaciones microscópicas para reconocer sus estructuras y utilizar herramientas de Biología Molecular para certificar su identidad (género y especie).
Existen diferentes especies de Trichoderma, pero en general, todas poseen un rápido crecimiento del micelio y abundante producción de esporas. Además, poseen una alta capacidad de adaptación a diferentes condiciones ambientales, que le permite crecer en un amplio rango de temperaturas y humedad, y colonizar suelos y superficies de diversas características.
Al inicio de su crecimiento, posee un color blanco amarillento que luego se convierte en verde cuando desarrolla sus estructuras de reproducción (esporas).